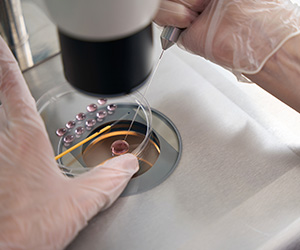
Когда лучше переносить эмбрион — на третий или на пятый день?

Эмбриолог — это специалист в области эмбриологии, которая изучает эмбрионы и их развитие. Они в основном работают в репродуктивной медицине, исследованиях или ветеринарии. В клинических условиях эмбриологи играют ключевую роль в лечении фертильности, например в экстракорпоральном оплодотворении (ЭКО). Их знания включают в себя обработку и изучение яйцеклеток, спермы и эмбрионов в лабораторных условиях для содействия зачатию.
Чтобы эффективно работать в области репродуктивной медицины и исследований, эмбриологи должны обладать академической квалификацией, техническим опытом и навыками межличностного общения. Обычно требуется степень в области биологии, биохимии, репродуктологии или смежной отрасли. Часто предпочитают научные степени в области клинической эмбриологии, репродуктивных наук или молекулярной биологии, особенно для руководящих должностей. Сертификация профессиональных организаций может улучшить перспективы карьерного роста.
Когда следует обратиться к врачу-эмбриологу
Обратиться к врачу-эмбриологу в случае следующих проблем и состояний:
- Длительный период бесплодия. Если пара пытается забеременеть в течение года или более (без успеха), это сигнал для обращения к специалисту. Для женщин старше 35 лет этот срок может сокращаться до шести месяцев.
- Проблемы с овуляцией. Если у женщины проблемы с регулярностью менструального цикла или отсутствием овуляции, это может быть индикатором необходимости консультации эмбриолога.
- Аномалии спермы. Если мужчина испытывает проблемы с количеством, качеством или подвижностью сперматозоидов, это может быть причиной бесплодия. Тестирование спермограмм и консультация эмбриолога могут помочь выбрать оптимальный метод лечения.
- Риск генетических болезней. Если у пары есть история генетических заболеваний или обнаружены хромосомные аномалии, врач-эмбриолог может рекомендовать применение методов, таких как преимплантационная генетическая диагностика (PGD).
- Выбор методов экстракорпорального оплодотворения (ЭКО). Для женщин, которые не могут забеременеть естественным путем, ЭКО становится наиболее эффективным методом. Врач-эмбриолог подбирает оптимальный протокол лечения.
- Использование донорских яйцеклеток или спермы. Если у пары есть трудности с наличием здоровых яйцеклеток или спермы, то врач может порекомендовать донорские варианты.
- Проблемы с имплантацией или частые выкидыши. Если пара пережила несколько неудачных попыток забеременеть или часто выбрасывает беременность, эмбриолог может помочь с подбором метода для улучшения шансов успешного зачатия и развития беременности.
Обращение к врачу-эмбриологу гарантирует высококвалифицированную помощь, что может значительно повысить вероятность наступления беременности в сложных случаях.
Какие современные репродуктивные технологии используют эмбриологи
Эмбриологи медицинского центра «Мати та дитина» применяют передовые репродуктивные технологии, чтобы помочь парам, которые сталкиваются с бесплодием. Вот некоторые из них:
- Внутриматочная инсеминация (ВМИ) — это метод, при котором обработанную сперму вводят непосредственно в матку женщины. Благодаря этому можно увеличить шансы на оплодотворение, особенно в случае бесплодия неясного генеза или физиологических проблем у пары.
- Экстракорпоральное оплодотворение (ЭКО) — это комплексная процедура, охватывающая стимуляцию яичников, оплодотворение яйцеклеток в лаборатории, культивирование эмбрионов и их последующий перенос в матку.
- Интрацитоплазматическая инъекция сперматозоида (ICSI) — во время этой процедуры сперматозоид вводится непосредственно в яйцеклетку. Этот метод применяется при тяжелых формах мужского бесплодия.
- Методы получения сперматозоидов при тяжелых формах бесплодия у мужчин, таких как TESA и MESA, которые предусматривают биопсию яичек для получения спермы.
- Вспомогательный хэтчинг — это метод лазерной обработки оболочки эмбриона для облегчения его имплантации в матке.
- Криоконсервация сперматозоидов — метод замораживания спермы для дальнейшего хранения и использования.
- Витрификация яйцеклеток и эмбрионов — безопасный способ замораживания яйцеклеток и эмбрионов для их сохранения на будущее.
- Донация яйцеклеток — используется при отсутствии собственных яйцеклеток у женщины.
- Преимплантационная генетическая диагностика (PGD) — выявление хромосомных аномалий эмбрионов до их имплантации в матку. Сотрудничество с генетиком и репродуктологом по интерпретации результатов тестов.
- Преимплантационный генетический скрининг (NGS) — современный метод для диагностики хромосомных аномалий или моногенных заболеваний эмбрионов.
- Селективная переносимость одного эмбриона — выбор одного из нескольких эмбрионов для переноски, чтобы снизить риск многоплодной беременности.
Часто задаваемые вопросы к эмбриологу, которые задают пары перед процедурами ВРТ
Как и когда происходит культивирование и отбор эмбрионов?
Культивирование эмбрионов начинается после оплодотворения яйцеклетки (ЭКО или ИКСИ). Эмбрионы развиваются в инкубаторе при оптимальных условиях (температура, влажность, кислород) в течение 3–5 дней. Отбор для переноски зависит от их качества и стадии развития. Оцениваются характеристики морфологии, симметрии клеток и деления.
Как оценивается качество эмбрионов и для чого это нужно?
Качество эмбрионов оценивается по морфологии, морфокинетике (скорость деления клеток) и генетическому анализу. Высококачественные эмбрионы повышают шансы успешной имплантации и беременности.
Можно ли определить пол ребенка?
Да, с помощью преимплантационной генетической диагностики (PGD) можно определить пол эмбриона, что особенно полезно для предотвращения наследственных заболеваний, связанных с полом.
Что делать, если эмбрионов больше, чем нужно?
Лишние эмбрионы могут быть заморожены (криоконсервация) для дальнейшего использования, если текущий цикл не станет успешным.
Может ли криоконсервация отрицательно повлиять на эмбрион?
Криоконсервация с помощью витрификации обычно безопасна, но имеется небольшой риск повреждения эмбрионов во время размораживания. Однако при правильно проведенной процедуре этот риск минимален.
Автор: Михайленко Надежда Анатольевна – эмбриолог.